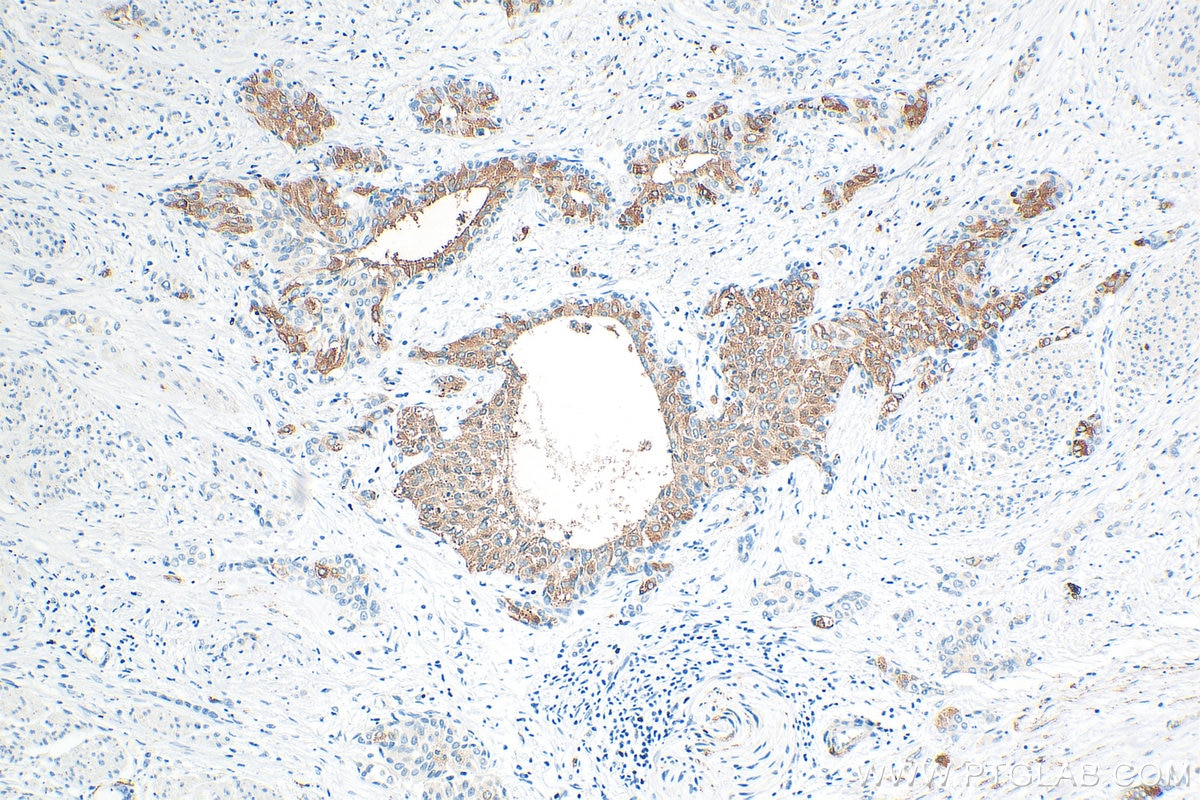
Immunohistochemistry (IHC) staining of human urothelial carcinoma tissue using ARHGAP44 Polyclonal antibody (32382-1-AP)
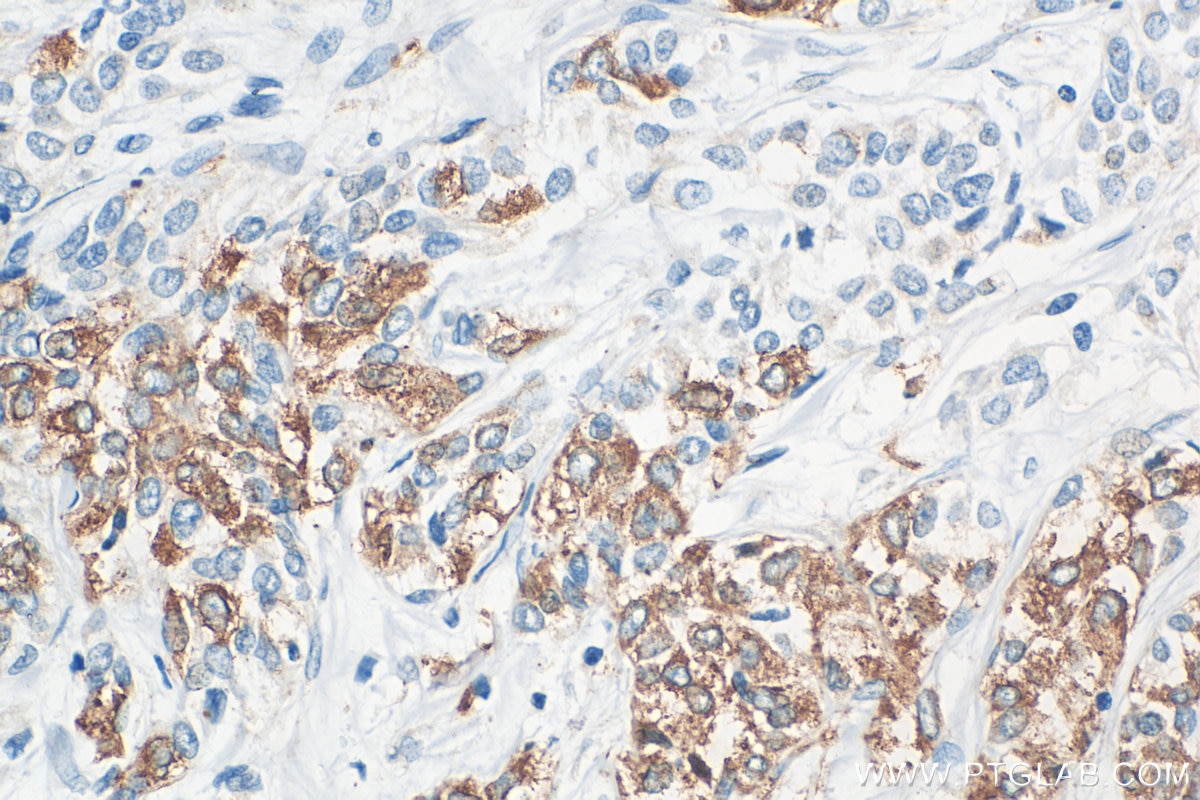
Immunohistochemistry (IHC) staining of human urothelial carcinoma tissue using ARHGAP44 Polyclonal antibody (32382-1-AP)

Tested Applications
| Positive WB detected in | HEK-293 cells, rat brain tissue, LNCaP cells |
| Positive IHC detected in | human urothelial carcinoma tissue Note: suggested antigen retrieval with TE buffer pH 9.0; (*) Alternatively, antigen retrieval may be performed with citrate buffer pH 6.0 |
| Positive IF/ICC detected in | HEK-293 cells |
Recommended dilution
| Application | Dilution |
|---|---|
| Western Blot (WB) | WB : 1:5000-1:50000 |
| Immunohistochemistry (IHC) | IHC : 1:750-1:3000 |
| Immunofluorescence (IF)/ICC | IF/ICC : 1:200-1:800 |
| It is recommended that this reagent should be titrated in each testing system to obtain optimal results. | |
| Sample-dependent, Check data in validation data gallery. | |
Product Information
32382-1-AP targets ARHGAP44 in WB, IHC, IF/ICC, ELISA applications and shows reactivity with human, rat samples.
| Tested Reactivity | human, rat |
| Host / Isotype | Rabbit / IgG |
| Class | Polyclonal |
| Type | Antibody |
| Immunogen |
CatNo: Ag38196 Product name: Recombinant human ARHGAP44 protein Source: e coli.-derived, PGEX-4T Tag: GST Domain: 580-772 aa of NM_001321166 Sequence: LQPGPERTSTTKSKELSPGSAQKGSPGSSQGTACAGTQPGAQPGAQPGASPSPSQPPADQSPHTLRKVSKKLAPIPPKVPFGQPGAMADQSAGQPSPVSLSPTPPSTPSPYGLSYPQGYSLASGQLSPAAAPPLASPSVFTSTLSKSRPTPKPRQRPTLPPPQPPTVNLSASSPQSTEAPMLDGMSPGESMST Predict reactive species |
| Full Name | Rho-type GTPase-activating protein RICH2 |
| Calculated Molecular Weight | 818aa, 89 kDa |
| Observed Molecular Weight | 80-100 kDa |
| GenBank Accession Number | NM_001321166 |
| Gene Symbol | RICH2 |
| Gene ID (NCBI) | 9912 |
| Conjugate | Unconjugated |
| Form | Liquid |
| Purification Method | Antigen affinity Purification |
| UNIPROT ID | Q17R89 |
| Storage Buffer | PBS with 0.02% sodium azide and 50% glycerol, pH 7.3. |
| Storage Conditions | Store at -20°C. Stable for one year after shipment. Aliquoting is unnecessary for -20oC storage. 20ul sizes contain 0.1% BSA. |
Background Information
Rho GTPase-activating protein 44 (ARHGAP44) belongs to the Rho GTPase-activating protein (RhoGAP) family, also known as Rich2.ARHGAP44 plays an important role in cytoskeletal dynamics, cellular motility and signaling. Its high expression in osteosarcoma correlates with tumor malignancy, suggesting its potential as a potential therapeutic target. In addition, ARHGAP44 may also be involved in the pathogenesis of diabetes and cardiovascular diseases, and its specific role in these diseases needs to be further investigated in the future.
Protocols
| Product Specific Protocols | |
|---|---|
| IF protocol for ARHGAP44 antibody 32382-1-AP | Download protocol |
| IHC protocol for ARHGAP44 antibody 32382-1-AP | Download protocol |
| WB protocol for ARHGAP44 antibody 32382-1-AP | Download protocol |
| Standard Protocols | |
|---|---|
| Click here to view our Standard Protocols |